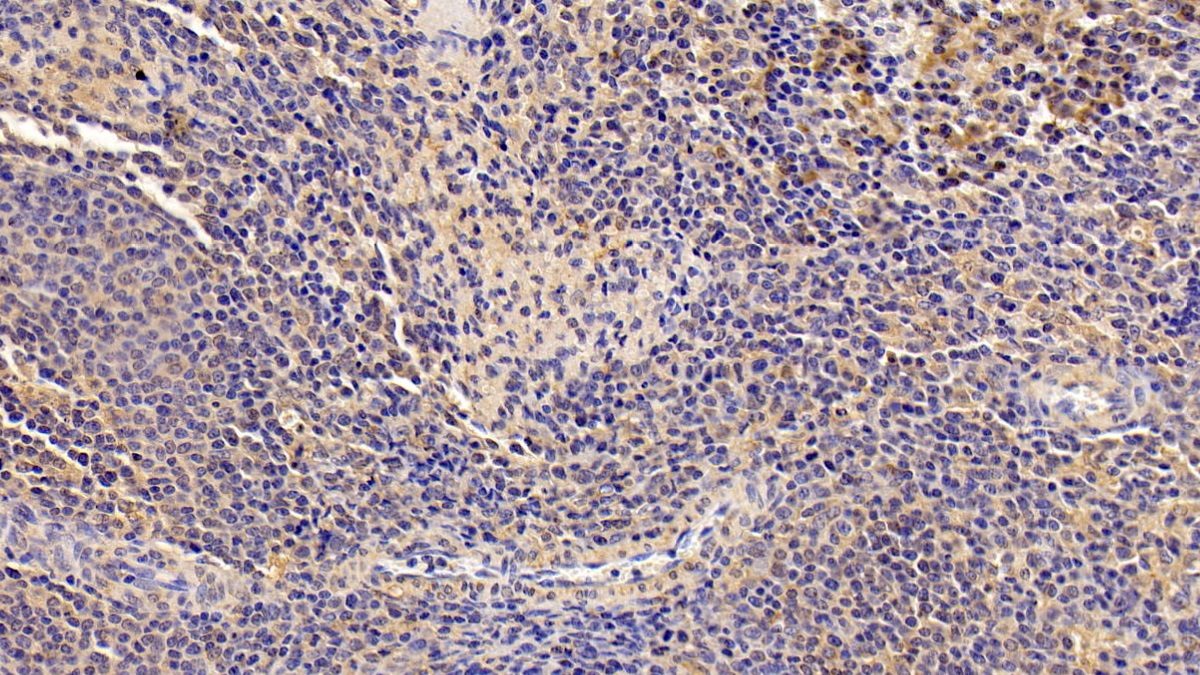

Polyclonal Antibody to Chitinase-3-like Protein 1 (CHI3L1)


Product No.: PAB463Hu01
Organism species: Homo sapiens (Human)
Monoclonal Antibody to Chitinase-3-like Protein 1 (CHI3L1)


Product No.: MAB463Hu22
Organism species: Homo sapiens (Human)

Polyclonal Antibody to Matrix Metalloproteinase 16 (MMP16)


Product No.: PAB533Hu01
Organism species: Homo sapiens (Human)
Monoclonal Antibody to Matrix Metalloproteinase 16 (MMP16)


Product No.: MAB533Hu22
Organism species: Homo sapiens (Human)

Polyclonal Antibody to Bone Marrow Stromal Cell Antigen 1 (BST1)


Product No.: PAB551Hu01
Organism species: Homo sapiens (Human)

Monoclonal Antibody to Bone Marrow Stromal Cell Antigen 1 (BST1)


Product No.: MAB551Hu22
Organism species: Homo sapiens (Human)

Polyclonal Antibody to Cluster Of Differentiation 23 (CD23)


Product No.: PAB582Hu01
Organism species: Homo sapiens (Human)

Monoclonal Antibody to Cluster Of Differentiation 23 (CD23)


Product No.: MAB582Hu22
Organism species: Homo sapiens (Human)

Polyclonal Antibody to S100 Calcium Binding Protein A9 (S100A9)


Product No.: PAB793Hu01
Organism species: Homo sapiens (Human)

Monoclonal Antibody to S100 Calcium Binding Protein A9 (S100A9)


Product No.: MAB793Hu22
Organism species: Homo sapiens (Human)

Polyclonal Antibody to Matrix Metalloproteinase 19 (MMP19)


Product No.: PAB853Hu01
Organism species: Homo sapiens (Human)
Monoclonal Antibody to Matrix Metalloproteinase 19 (MMP19)


Product No.: MAB853Hu22
Organism species: Homo sapiens (Human)

Polyclonal Antibody to Syndecan 4 (SDC4)


Product No.: PAB939Hu01
Organism species: Homo sapiens (Human)
Monoclonal Antibody to Syndecan 4 (SDC4)


Product No.: MAB939Hu22
Organism species: Homo sapiens (Human)
Polyclonal Antibody to Interleukin 4 Receptor (IL4R)

